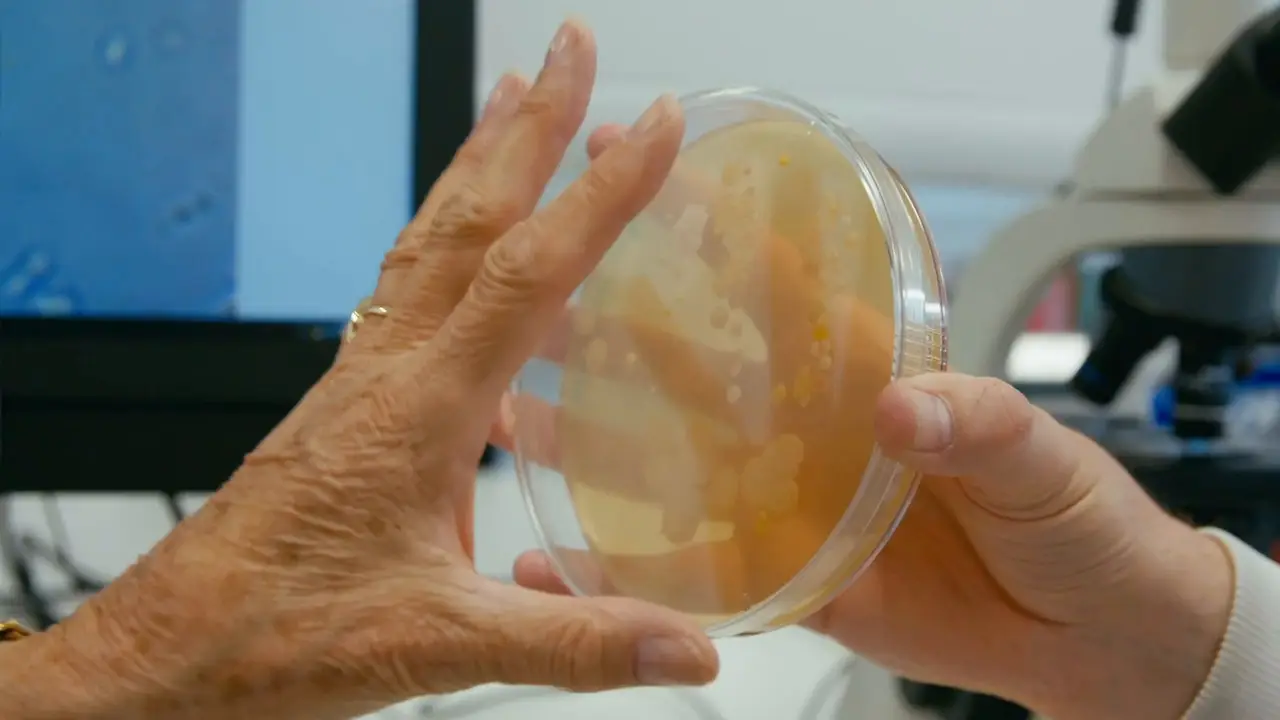
BBC - The Truth About: Antibiotics (2019)

BBC - The Truth About: Antibiotics (2019)
HDTV | 1280x720 | .MKV/AVC @ 2086 Kbps | 58 min 6 s | 920 MiB
Audio: English AAC 123 kbps, 2 channels | Subs: None
Genre: Documentary
Wild alligators and a sewage works are just two of the places Angela Rippon discovers that scientists are looking for new ways to fight bacterial infections. Angela reveals how a growing number of bacterial diseases are becoming resistant to the antibiotics currently in use. If nothing is done, millions could die. Angela investigates the latest scientific breakthroughs, meets a GP on the front line in the fight against infection and finds out how we can all take part in the effort to keep the miracle cure effective.
General
Complete name : The.Truth.About.Antibiotics.2019.720p.mkv
Format : Matroska
Format version : Version 4 / Version 2
File size : 920 MiB
Duration : 58 min 6 s
Overall bit rate : 2 213 kb/s
Video
ID : 1
Format : AVC
Format/Info : Advanced Video Codec
Format profile : High@L4.1
Format settings, CABAC : Yes
Format settings, ReFrames : 5 frames
Codec ID : V_MPEG4/ISO/AVC
Duration : 58 min 6 s
Width : 1 280 pixels
Height : 720 pixels
Display aspect ratio : 16:9
Frame rate mode : Constant
Frame rate : 25.000 FPS
Color space : YUV
Chroma subsampling : 4:2:0
Bit depth : 8 bits
Scan type : Progressive
Writing library : x264 core 157 r2935 545de2f
Encoding settings : cabac=1 / ref=5 / deblock=1:0:0 / analyse=0x3:0x113 / me=hex / subme=8 / psy=1 / psy_rd=1.00:0.00 / mixed_ref=1 / me_range=16 / chroma_me=1 / trellis=2 / 8x8dct=1 / cqm=0 / deadzone=21,11 / fast_pskip=1 / chroma_qp_offset=-2 / threads=12 / lookahead_threads=2 / sliced_threads=0 / nr=0 / decimate=1 / interlaced=0 / bluray_compat=0 / constrained_intra=0 / bframes=3 / b_pyramid=2 / b_adapt=1 / b_bias=0 / direct=3 / weightb=1 / open_gop=0 / weightp=2 / keyint=250 / keyint_min=25 / scenecut=40 / intra_refresh=0 / rc_lookahead=50 / rc=crf / mbtree=1 / crf=20.0 / qcomp=0.60 / qpmin=0 / qpmax=69 / qpstep=4 / ip_ratio=1.40 / aq=1:1.00
Language : English
Default : Yes
Forced : No
Color range : Limited
Matrix coefficients : BT.709
Audio
ID : 2
Format : AAC
Format/Info : Advanced Audio Codec
Format profile : LC
Codec ID : A_AAC
Duration : 58 min 6 s
Channel(s) : 2 channels
Channel positions : Front: L R
Sampling rate : 48.0 kHz
Frame rate : 46.875 FPS (1024 spf)
Compression mode : Lossy
Language : English
Default : Yes
Forced : No
Screenshots: